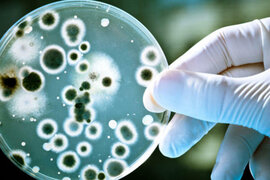
.

Xəbərlər
Dirsək oynağının çıxıqları
Bu çıxıqlar yuxarı ətraflarda ən çox rast gəlinən travmalarından biridir. Dirsək oynağı çox mürəkkəb quruluşa malikdir. Onun əmələ gəlməsində 3 sümük: mil, dirsək (said) və bazu sümükləri iştirak edirlər. Travma nəticəind
Dizləriniz niyə xırçıldayır?
Sizlərdən çoxunuz yəqin ki, hərəkət edən zaman dizlərinizin xırçıldadığını eşitmisiniz. Hətta bəzi hallarda bu səs dizlərdə ağrı hissiyatı ilə birgə insanda narahatçılıq hissi yaradır. Bəzən pillənkən qalxıb enən zaman di
Artıq cəsədlər basdırılmır, gübrəyə çevrilir - Dünya şokda
Nyu York ştatı cəsədləri gübrəyə çevirmək qərarı verib. Gübrələmə tərəfdarları bunun ekoloji cəhətdən təmiz bir üsul olduğunu və bir çox şəhərlərdə qəbiristanlıq problemini də həll edəcəyini iddia edirlər. -a istinadən bildiri
Avropada qrip epidemiyası: Dərman çatışmazlığı yaşanır
COVID-19-un təsirini itirməyə başladığı Avropada qrip və onun törəmə tənəffüs xəstəliklərinin ciddi şəkildə artması həyata mənfi təsir edir, bir çox ölkədə isə antibiotik kimi dərmanların tədarükündə çətinliklər yaşanır
Salmanelyoz
Salmanelyoz kəskin infeksion xəstəlik olub müxtəlif bağırsaq patologiyaları ilə özünü biruzə verən xəstəlikdir. Xəstəlik qastroenterit və ağır sepsis əlamətləri ilə özünü biruzə verir. Xəstəliyin əmələ gəlməsini salmanell

Stafilokokk xəstəlikləri
Stafilokokk bakteriyaları hər bir yerdə tapılması mümkün olan bakteriyalardır. Onlara insanın ağzında, burnunda və hətta dəri toxumasının üstündə də rast gəlmək olur. İnsanın orqanizmi sağlam olduqda stafilokokklar heç bi

Yastıayaqlılıq
Yastıayaqlılıq (düzdabanlıq) anadangəlmə və qazanılma olur. Qazanılmış yastıayaqlılıq uyğun olmayan ayaqqabı geyildiyi zaman meydana çıxır. Düzgün, ortapedik olmayan ayaqqabı ayaq sümüklərinin deformasiyasına səbəb ola bilir

Sınıqlar
Sınıqlar açıq və qapalı ola bilər. Qapalı sınıqlar zamanı sümük sınır və ya çatlayır və dəri öz tamlığını saxlayır. Açıq sınıqlar zamanı dəri də zədələnir, sümük sınaraq dəridən kənara çıxır. Açıq sınıqlarda infeksiya ol

Xroniki B hepatiti
Xroniki B hepatit çox vaxt az simptomlu gedişə malik olur. Diaqnoz əksər hallarda laborator müayinələrin nəticəsinə əsasən retrospektiv qoyulur və ancaq bundan sonra xəstə retrospektiv olaraq xəstəliyin daha erkən təzahürlərin

Koronavirusun yeni növü yayılır - Dünyada yenə həyəcan təbili - Simptomlar belədir
Alimlər "XBB.1.5" adlı yeni variantın aşkarlandığını elan edərək, kritik xəbərdarlıqlar ediblər. -a istinadən bildirir ki,müvafiq olaraq, "XBB.1.5" koronavirusun əvvəlki növləri ilə müqayisədə daha sürətl

İş yerində ölüm hadisələrinin səbəbi araşdırılıb - Başlıca səbəb
Rusiyalı ekspertlər iş yerlərində adamların ölümünün səbəblərini təhlil ediblər. xəbər verir ki, buna səbəb Rusiyada 2017-ci ildə 2,6 min insanın iş yerində vəfat etməsidir. Aparılan araşdırmaladan məlub olub ki, ürək-dama

Bunu edən hamilələrin uşaqları balacaboy olur - Araşdırma
Amerika alimləri hamiləlikdə çox qəhvə içməyin doğulacaq uşağa təsirini araşdırıb. -s istinadla xəbər verir ki, hamiləliyin ilk 3 ayında hətta normal dozada qəhvə içən qadınların uşaqların boyu orta boy hündürlüyündən dah

Yumurtanı bu halda yemək zərərli mikrob yaradır
Mütəxəssislər çiy yumurtanın zərərli olduğunu açıqlayıblar. xəbər verir ki, ekspertlərin sözlərinə görə, çiy yumurtanın iki zərəri var. Çiy yumurta B7 vitamini qəbulunu ləngidir. Digər zərəri isə salmonella mikrobu əməl

Yeni doğulmuş uşaqlar niyə səpir?
Əksər yeni doğulmuş körpələrdə bir çox fərqli-fərqli səpkilərə rast gəlirik. Bu isə əksər valideynlərdə narahatlıq hissi doğurur. xəbər verir ki, uzman pediatr Altay Abdullaoğlunun sözlərinə görə, bu səpkilər bir çox hallard

Yuxuda qəfil ölümün səbəbi BUDUR
Kardioloq Andrey Kondraxin yaşdan asılı olmayaraq, yuxuda qəfil ölümün səbəblərini açıqlayıb. -a istinadla xəbər verir ki, bəzi xəstəlik və faktorlar yuxuda qəfil ölüm riskini artırır. Adətən ürək-damar problemləri olanlard

Artriti yaradan səbəblər və onunla mübarizə
Revmatoloji xəstəliklərin ilkin əlamətlərindən biri oynağın iltihabi xəstəliyi olan artritdir. AZƏRTAC xəbər verir ki, həkim-revmatoloq Nərgiz Hüseynova deyib: "Artrit oynaqlarda qızartı, şişkinlik, ağrı şikayəti il
Hər gün toxunduğumuz ən çirkli 5 ƏŞYA
Amerika alimləri xüsusi avadanlığın köməyi ilə bizi əhatə edən müxtəlif əşyaların üzərində olan mikrobların sıxlığını yoxlayıblar. Bu göstəriciyə görə ən çirkli 5 əşya təyin olunub:. 1. Pul. 2. İctimai nəqliyyatda tutacaqlar

Bu qidalarla qalxanvari vəz probleminizi AZALDIN
Əksər insan qalxanvari vəzin xəstəliyindən əziyyət çəkirlər. Bəzi dərman və qidalarla xəstəliyin irəliləməsinin qarşısını almaq olar. Qalxanvari vəzinin normal fəaliyyəti üçün bu 3 maddə olduqca vacibdir: yod, selen və tirozi

Limonun üstünə duz, istiot səpib yeyin – 9 xəstəliyə kömək edir
Limon diliminin üzərinə qara istiot, dəniz duzu səpib, sonra istifadə etsəniz, daha çox fayda əldə edə bilərsiz. bu üsulun sağalda biləcəyi xəstəlikləri təqdim edir:. Boğaz ağrısı, angina - limon suyu, istiot, dəniz duzunu

Bu yeməkləri ikinci dəfə qızdırmaq OLMAZ
Bir çox yeməkləri ikinci dəfə qızdıraraq istifadə edirik. Ancaq mütəxəssislər isə bu fikrin əleyhinədirlər. xəbər verir ki, mütəxəssislər bəzi yeməkləri qızdırmağın ölümə bərabər olduğunu qeyd ediblər. Çünki təkrar qızdırılm

Soyuq olmasa belə üşüyürsünüzsə, OXUYUN
Hava çox soyuq olmayanda belə üşüyürsünüzsə, bu, bir çox xəstəliklərin xəbərçisi ola bilər. Belə ki, bu xəstəliklərin ən birincisi qanda dəmirin azalması ilə baş verən anemiyadır. Bundan əlavə, ateroskleroz və anoreksiy

Şəkərli diabet xəstəliyinin 5 tipi– Gizli şəkər nədir?
Ümumdünya Səhiyyə Təşkilatının statistikasına görə, 1980-ci ildən bu yana şəkərli diabet xəstəliyinə tutulanların sayı 433 milyona çatıb. Əgər 30 il əvvəl diabet haqqında yalnız xəstələr və həkimlər danışırdısa, bu gün diabeti

Kivinin 10 faydası
Kivi kiçik bir meyvə olmasına baxmayaraq, faydaları çoxdur. Əsil vətəni Çindir. Kivinin faydaları ilə tanış olaq:. 1. Kivinin təxminən 100 qr-da 98 milliqr. C vitamini vardır. Kivini səhər yeməklərində yemək məsləhət görülür

Hər gün göy soğan yeyin! FAYDALARI
Göy soğanı təbii antiseptik və antibiotik adlandırmaq olar. Onun tərkibində olan bir çox faydalı maddələr mikrobları, virusları, göbələkləri öldürür, immun sistemini gücləndirir, iltihabı azaldır. - Göy soğan C vitamini il

Vətən haqqında bayatılar
Ehtiraslı öpüşmək üçün bunlara mütləq əməl edin
Qaravəllilər
Arzuolunmaz hamiləlik
Azərbaycanda uşaqlar arasında yeni xəstəlik yayılır - XƏBƏRDARLIQ
Enerji içkisinə görə şikəst qaldı
Kivini qabığını soymadan yeyin
Səsimdən başqa hər yerim əməliyyatla düzəlib' - Ülviyyədən etiraf
Bu vitamin çatışmırsa insan daim əsəbi olur
Emre Altuğ sabah Moskvada konsert verəcək
Ev dustağı olan rusiyalı bloger dördüncü övladına hamilədir
İradədən boşanması haqda çıxan xəbərlərə CAVAB
Ürək üçün faydalıdır deyə ovuc-ovuc yeyilir- qaraciyəri məhv edirmiş
Dilarədən sürpriz tərz: "Mamma mafia" - FOTOLAR
Yaşı 50-dən yuxarı kişilər mütləq bu müayinədən keçməlidir